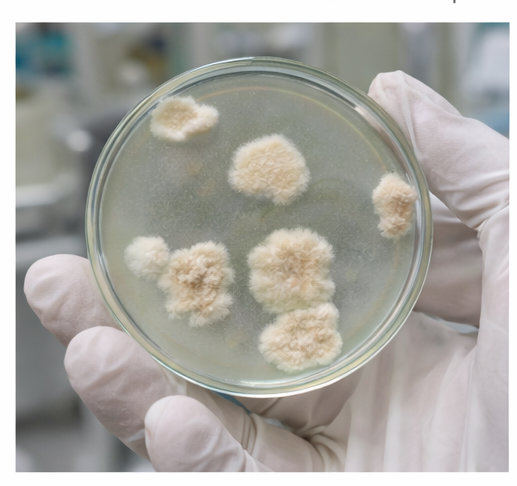

Sporotrichosis is a subacute to chronic fungal infection caused by Sporothrix schenckii, a dimorphic fungus found in soil, decaying vegetation, and organic matter. The most common clinical presentation is lymphocutaneous sporotrichosis, characterized by nodular lesions that spread along regional lymphatic channels following traumatic inoculation. Due to its variable presentation, sporotrichosis is frequently misdiagnosed as bacterial infection, cutaneous tuberculosis, or atypical mycobacterial disease. We report a case of lymphocutaneous sporotrichosis in an adult patient presenting with multiple painless nodular lesions arranged linearly along the lymphatic drainage of the upper limb. The diagnosis was confirmed by microbiological and clinical correlation, and the patient responded well to antifungal therapy. This case highlights the importance of early recognition of sporotrichoid spread patterns and timely initiation of appropriate antifungal treatment to prevent disease progression.
Sporotrichosis is an implantation mycosis caused by the Sporothrix schenckii complex, endemic in tropical and subtropical regions [1,2]. Infection typically occurs following minor skin trauma, such as a thorn prick or splinter injury, leading to inoculation of the organism into the dermis or subcutaneous tissue [3]. The lymphocutaneous form is the most frequently encountered clinical variant and is characterized by the development of nodular lesions that progress proximally along lymphatic channels, a pattern commonly referred to as “sporotrichoid spread” [4].
The condition often poses a diagnostic challenge, as the lesions may mimic bacterial cellulitis, cutaneous leishmaniasis, nocardiosis, or atypical mycobacterial infections [5]. Delayed diagnosis may result in prolonged morbidity and unnecessary antibiotic use. Awareness of characteristic clinical features, particularly nodular lymphangitic spread in patients with relevant environmental exposure, is crucial for early diagnosis and effective management.
A middle-aged adult patient presented with multiple painless skin lesions over the upper limb that had gradually progressed over a period of several weeks. The condition began as a small, erythematous papule at the site of minor trauma sustained while handling soil and plant material during routine gardening activities. The patient recalled a trivial injury caused by a thorn or splinter but did not initially seek medical attention, as the lesion was asymptomatic and non-pruritic.

Over the subsequent weeks, the primary lesion enlarged slowly, and additional subcutaneous nodules appeared proximally along the same limb, following the course of regional lymphatic drainage. These secondary lesions developed in a linear, ascending pattern and were similar in appearance to the initial papule, remaining firm, painless, and non-fluctuant. None of the nodules were associated with significant erythema, warmth, or purulent discharge.

There was no history of fever, malaise, weight loss, or other systemic symptoms. The patient denied any history of immunosuppression, diabetes mellitus, long-term corticosteroid use, or chronic medical illness. There were no prior similar episodes, and no history of recent travel, animal bites, or exposure to individuals with infectious skin diseases. Apart from the progressively increasing cutaneous lesions, the patient reported no functional limitation of the affected limb and remained otherwise in good general health.
Dermatological examination revealed multiple firm, well-defined nodular lesions distributed along the upper limb, arranged in a linear pattern corresponding to the course of the superficial lymphatic vessels. The nodules varied in color from erythematous to skin-colored and were clearly demarcated from the surrounding skin. Lesion size ranged from small papules to larger subcutaneous nodules, giving the appearance of stepwise progression along the limb.
Some of the lesions demonstrated central crusting and shallow ulceration, suggesting localized breakdown of the overlying epidermis, while others remained dome-shaped with intact skin surfaces. There was no evidence of active purulent discharge, bleeding, or necrosis. On palpation, the nodules were non-tender, firm in consistency, and non-fluctuant, indicating the absence of abscess formation. The surrounding skin showed no significant erythema, warmth, or induration, effectively ruling out acute bacterial cellulitis.
Examination of regional lymph nodes revealed minimal lymphadenopathy without tenderness or matting. Systemic examination was unremarkable, with no signs of fever, organomegaly, or disseminated infection. The absence of systemic involvement, coupled with the characteristic ascending linear arrangement of nodules along lymphatic channels, strongly raised clinical suspicion of lymphocutaneous sporotrichosis and prompted further targeted diagnostic evaluation.
Routine hematological and biochemical parameters were within normal limits. Bacterial cultures were negative. Fungal culture of aspirated material from one of the nodules demonstrated growth consistent with Sporothrix schenckii, confirming the diagnosis. Histopathological examination, where performed, showed granulomatous inflammation with mixed inflammatory infiltrates, supporting the clinical and microbiological findings [2,4].
The patient was initiated on oral itraconazole, which is the treatment of choice for cutaneous and lymphocutaneous sporotrichosis [6]. Therapy was continued for several weeks, with gradual regression of nodular lesions and complete resolution of ulceration. No adverse effects were noted during treatment. The patient demonstrated excellent clinical response, with complete healing of lesions and no evidence of recurrence at follow-up. Early antifungal therapy prevented further lymphatic spread and ensured favorable clinical outcome.


Lymphocutaneous sporotrichosis represents the most common and classic clinical presentation of sporotrichosis and is characteristically distinguished by the development of nodular lesions that spread progressively along lymphatic channels from the primary site of inoculation [1,3]. This ascending, linear pattern often referred to as sporotrichoid spread—is a critical diagnostic clue and should immediately prompt consideration of sporotrichosis in the appropriate clinical context. The condition is particularly associated with occupational or environmental exposure to soil, decaying vegetation, sphagnum moss, or plant material, and is frequently observed among gardeners, farmers, florists, and individuals involved in outdoor or agricultural activities.
Despite its distinctive clinical pattern, sporotrichosis is often misdiagnosed, especially in its early stages, leading to inappropriate empirical antibiotic therapy and delayed initiation of antifungal treatment [5]. The indolent progression, absence of systemic symptoms, and non-specific appearance of early lesions contribute to diagnostic confusion with bacterial lymphangitis, atypical mycobacterial infections, nocardiosis, or cutaneous tuberculosis. Such delays can result in prolonged disease duration, unnecessary investigations, and increased patient morbidity.
Definitive diagnosis relies on isolation of Sporothrix schenckii through fungal culture, which remains the gold standard for confirmation [2,6]. However, due to the slow-growing nature of the organism, a high index of clinical suspicion is essential to initiate timely and appropriate therapy while awaiting microbiological confirmation. Itraconazole has largely replaced potassium iodide as the first-line treatment owing to its superior efficacy, improved tolerability, and favorable safety profile. With early recognition and appropriate antifungal therapy, the prognosis of lymphocutaneous sporotrichosis is excellent, and complications are uncommon in immunocompetent individuals.
Lymphocutaneous sporotrichosis should be considered in patients who present with painless nodular lesions arranged in a linear or ascending pattern along the course of lymphatic channels, particularly when there is a history of minor cutaneous trauma and exposure to soil, plant matter, or decaying vegetation. This clinical presentation, known as sporotrichoid spread, is a hallmark feature of the disease and serves as a critical diagnostic clue in distinguishing sporotrichosis from other infectious and non-infectious dermatological conditions.
Recognition of this characteristic pattern is essential to differentiate lymphocutaneous sporotrichosis from bacterial lymphangitis, atypical mycobacterial infections, nocardiosis, and cutaneous tuberculosis, which may present with similar nodular or ulcerative lesions. Failure to consider sporotrichosis in the differential diagnosis often results in repeated courses of ineffective antibacterial therapy, unnecessary investigations, and delayed initiation of appropriate antifungal treatment.
Early diagnosis, supported by microbiological confirmation through fungal culture, enables prompt initiation of targeted antifungal therapy, most commonly with itraconazole. Timely treatment leads to gradual regression of lesions, complete clinical resolution, and excellent long-term prognosis in the majority of immunocompetent patients. Increased clinician awareness of this classic yet frequently overlooked presentation is therefore crucial to prevent diagnostic delays, reduce unnecessary antibiotic use, and minimize patient morbidity. With early recognition and appropriate management, lymphocutaneous sporotrichosis remains a highly treatable condition with consistently favorable clinical outcomes.
Read more such content on @ Hidoc Dr | Medical Learning App for Doctors
1.
Potential new therapy for childhood brain cancer could heal treatment-resistant tumors
2.
Investigating the Relationship Between GERD and Anxiety/Depression.
3.
In a clinical trial, "3D mammography" nearly reduces the incidence of breast cancer between two screening exams.
4.
Indoor hydroponic gardening can improve mental health and quality of life for cancer patients
5.
Dr. Prerana S. Nesargi's message for Childhood Cancer Awareness Month 2023 is to increase understanding of pediatric oncology.
1.
How AI, Multi-Omics, and Real-World Evidence are Redefining Oncology Research and Shaping Cancer Care?
2.
Value, Access, and Affordability in Next-Gen Oncology: Navigating Costs, Coverage, and Clinical Impact
3.
Vaccines that can help prevent cancer
4.
Innovative Strategies in Prostate Cancer Management: From Surveillance to Systemic Therapies
5.
Revolutionizing Cancer Treatment: Harnessing the Power of AI in Histopathology
1.
International Lung Cancer Congress®
2.
Genito-Urinary Oncology Summit 2026
3.
Future NRG Oncology Meeting
4.
ISMB 2026 (Intelligent Systems for Molecular Biology)
5.
Annual International Congress on the Future of Breast Cancer East
1.
Molecular Contrast: EGFR Axon 19 vs. Exon 21 Mutations - Part I
2.
ESMO Breast Cancer 2022: P Reality X- A Restrospective Analysis
3.
A Comprehensive Guide to First Line Management of ALK Positive Lung Cancer - Part VI
4.
First Line Combination Therapy- The Overall Survival Data in NSCLC Patients
5.
Evolving Space of First-Line Treatment for Urothelial Carcinoma- Case Discussion
© Copyright 2026 Hidoc Dr. Inc.
Terms & Conditions - LLP | Inc. | Privacy Policy - LLP | Inc. | Account Deactivation